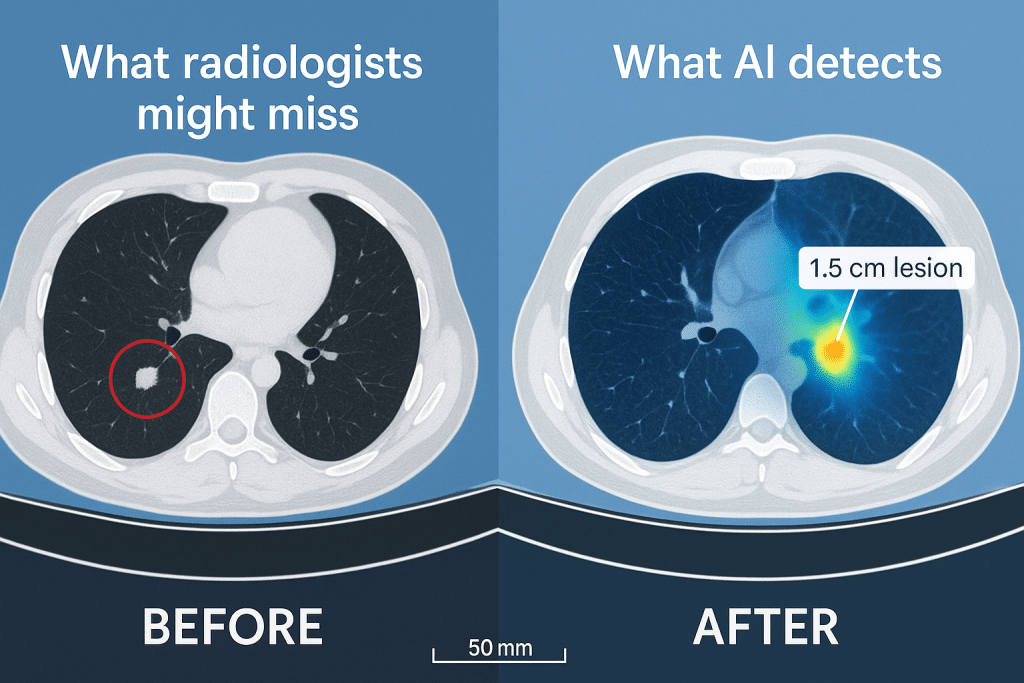
Before/After comparison showing a CT scan with a tiny tumor circled

The Detection Revolution We’ve Been Waiting For
AI Cancer Detection – We’re living through a medical revolution that’s happening right now, in hospitals and clinics across the globe. Artificial intelligence isn’t just assisting doctors anymore—it’s fundamentally transforming how we detect, diagnose, and fight cancer. And the results from 2025 are nothing short of extraordinary.
Imagine an AI system that can spot cancer with 99% accuracy, detecting tumors so small and subtle that even expert radiologists might miss them. Or picture a technology that can predict whether a patient will survive their cancer diagnosis with 75% accuracy—more than 10 percentage points better than traditional methods. These aren’t sci-fi fantasies. These are real technologies deployed in real hospitals, saving real lives today.
The bottom line: AI-powered cancer detection has moved from experimental promise to clinical reality, with multiple systems now achieving accuracy rates that match or exceed human experts while processing scans in seconds rather than hours.
The Numbers That Tell the Story
Let’s start with some jaw-dropping statistics from 2025 that show just how far we’ve come:
In Germany, a nationwide study involving 463,094 women across 12 sites demonstrated that AI-supported mammography screening increased breast cancer detection rates by 17.6% without increasing false positives. We’re talking about real women whose cancers were caught earlier because of AI—cancers that might have been missed with traditional screening alone.
Harvard Medical School’s CHIEF (Clinical Histopathology Imaging Evaluation Foundation) model achieved nearly 94% accuracy in detecting cancer across 15 different datasets containing 11 cancer types. When we zoom in on specific applications, the numbers get even more impressive: 96% accuracy for detecting EZH2 mutations in lymphoma, 89% accuracy for BRAF in thyroid cancer, and 91% accuracy for NTRK1 in head and neck cancers.
But perhaps the most remarkable breakthrough comes from researchers at Charles Darwin University and Australian Catholic University, who developed the ECgMLP model. This AI achieved 99.26% accuracy in detecting endometrial cancer from histopathology images—dramatically outperforming the current human-led diagnostic accuracy of just 78-80%.

How Actually AI Cancer Detection Works : Breaking Down the Technology
So how does this technology actually work? We’re not talking about magic—we’re talking about sophisticated machine learning algorithms trained on millions of medical images.
The Deep Learning Advantage
Modern AI cancer detection systems use deep learning neural networks—computer systems that can learn to recognize patterns in medical images just like our brains learn to recognize faces. But here’s what makes them special: these systems can process and analyze thousands of subtle features that the human eye simply cannot perceive.
When a radiologist examines a mammogram, they’re looking for known patterns and abnormalities based on their training and experience. AI systems, however, can simultaneously analyze texture, density, shape, spatial relationships, and hundreds of other quantitative features across the entire image—all in seconds.
Foundation Models: The ChatGPT of Medical Imaging
One of the most exciting developments in 2025 is the emergence of foundation models for cancer detection. Just as ChatGPT can handle various language tasks, these AI systems can perform multiple diagnostic tasks across different cancer types.
Harvard’s CHIEF model exemplifies this approach. Rather than being trained for one specific task (like detecting breast cancer), CHIEF can detect cancer cells, identify tumor origins, predict patient outcomes, and even determine which treatments might work best—all from analyzing pathology slides. This versatility, combined with the fact that it works equally well regardless of how tissue samples were obtained or digitized, represents a massive leap forward in clinical utility.

Real-World Breakthroughs Happening Right Now
China’s Multi – AI Cancer Detection System
Chinese researchers have unveiled AI systems that are changing the game for some of cancer’s deadliest forms. The GRAPE model, developed through collaboration between Zhejiang Cancer Hospital and Alibaba’s DAMO Academy, can detect early-stage stomach cancer from standard CT scans—a method previously considered relatively ineffective for gastric cancer screening.
Even more impressive is the PANDA system for pancreatic cancer, one of medicine’s most elusive killers. In clinical trials, PANDA demonstrated 92.9% sensitivity and 99.9% specificity for cancer detection. The system received FDA Breakthrough Device Designation in April 2025 and has already screened over 40,000 people at the People’s Hospital Affiliated with Ningbo University, detecting two early pancreatic cancer cases that were missed by routine tests.
Predicting the Future: Stanford’s MUSK Model
Perhaps most remarkable is Stanford Medicine’s MUSK (Multimodal Understanding System for Oncology Knowledge) model, which doesn’t just detect cancer—it predicts outcomes. By combining microscopic pathology images with clinical text data, MUSK accurately predicted disease-specific survival 75% of the time across all cancer types, compared to just 64% accuracy for standard clinical predictions.
For non-small cell lung cancer patients, MUSK identified those who would benefit from immunotherapy with 77% accuracy, far surpassing the standard PD-L1 expression method’s 61% accuracy. We’re talking about better matching patients to treatments that could save their lives while sparing others from ineffective therapies and their side effects.
The Clinical Impact: From Lab to Patient Care
These aren’t just impressive numbers in research papers—they’re translating into real clinical outcomes. AI-powered screening is already being deployed in hospitals worldwide, and the results are transforming patient care.
Earlier Detection Means Better Outcomes
We know that early detection is crucial for cancer survival. AI systems are catching cancers months or even years earlier than traditional methods. Studies show that AI can retrospectively identify 20-40% of interval cancers—those that appear between regular screening appointments—that were visible on previous mammograms but missed by radiologists.
In the German nationwide mammography study, the AI-supported screening group achieved a cancer detection rate of 6.7 per 1,000 screenings, compared to 5.7 per 1,000 in the control group. This 17.6% increase means more women getting diagnosed and treated earlier, when their cancers are most treatable.
Reducing the Diagnostic Burden
Here’s something we don’t talk about enough: radiologists and pathologists are overwhelmed. The volume of medical imaging has exploded, and there simply aren’t enough human experts to keep up. This workload pressure can lead to fatigue and missed diagnoses.
AI doesn’t get tired. It doesn’t have bad days. It can process thousands of scans with consistent accuracy, flagging suspicious cases for human review and allowing experts to focus their time and expertise where it’s needed most. Studies using tools like Paige Prostate (the first FDA-approved AI pathology tool) showed a 70% reduction in false negative diagnoses and a 24% reduction in false positives when pathologists used AI assistance.

Beyond AI Cancer Detection: AI’s Expanding Role
While detection is crucial, AI’s role in cancer care extends far beyond identifying tumors on scans.
Precision Treatment Selection
AI systems are now helping oncologists choose the most effective treatments for individual patients. Roche’s VENTANA TROP2 RxDx Device, which received FDA Breakthrough Device Designation in April 2025, uses computational pathology to analyze lung cancer tissue and compute quantitative TROP2 scores. This helps identify patients with non-small cell lung cancer who are most likely to benefit from specific targeted therapies.
The algorithm incorporates AstraZeneca’s Quantitative Continuous Scoring platform, enabling diagnostic precision impossible with traditional manual scoring methods. We’re moving toward a future where every patient receives the treatment most likely to work for their specific cancer, rather than one-size-fits-all approaches.
Genomic Profiling and Biomarker Discovery
Modern AI systems can predict genetic mutations and biomarker profiles just by analyzing tissue images. Harvard’s CHIEF model successfully identified features associated with several important genes related to cancer growth and suppression, predicting key genetic mutations related to treatment response with impressive accuracy.
This capability is revolutionary because traditional genetic testing requires separate molecular analysis that can take days or weeks and add significant costs. AI can provide these insights immediately from routine pathology slides, speeding up treatment decisions when every day counts.
The Challenges We’re Still Facing
Despite these remarkable advances, we need to be honest about the challenges and limitations that remain.
The Bias Problem
AI systems are only as good as the data they’re trained on. If training datasets predominantly contain images from certain demographic groups, the AI may perform less accurately for underrepresented populations. Research has shown that AI models can exhibit reduced accuracy when applied to racial, ethnic, or gender groups that were underrepresented in training data.
This is an ethical imperative we must address. Cancer doesn’t discriminate, and neither should our detection technologies. Researchers and developers are working to build more diverse training datasets, but this remains an active area of concern and improvement.
The Black Box Problem
Many AI systems, particularly deep learning models, function as “black boxes”—they arrive at conclusions through complex neural networks that even their creators can’t fully explain. When an AI flags a suspicious region on a scan, it’s often difficult to understand exactly why it made that determination.
This lack of interpretability raises important questions: How can doctors trust and act on AI recommendations they don’t fully understand? Who is responsible when an AI system makes an error? How much should remain under human control? These aren’t just technical questions—they’re ethical and legal challenges that the medical community is actively grappling with.
Data Quality and Standardization
AI systems require enormous amounts of high-quality, well-labeled training data. But medical images come from different scanners, different hospitals, with different protocols and standards. This variability can affect AI performance when systems encounter data that differs from their training sets.
Efforts are underway to standardize imaging protocols and create more robust AI models that can handle this variability, but it remains a significant challenge for widespread deployment.

The Human Element: AI as Partner, Not Replacement
Here’s something crucial to understand: AI is designed to assist, not replace, medical professionals. The best results occur when AI and clinicians work collaboratively.
Studies consistently show that the combination of AI and human expertise outperforms either alone. Radiologists using AI assistance can process cases more quickly while maintaining or improving accuracy. They can focus their expertise on complex, ambiguous cases while AI handles routine screening and flags potential concerns.
Dr. Kun-Hsing Yu from Harvard Medical School, senior author of the CHIEF study, emphasized this partnership: “We wanted to leverage multiple types of data to gain more insight and get more precise predictions about patient outcomes.” The goal isn’t to automate doctors out of existence—it’s to give them superpowers.
What the Future Holds
As we look beyond 2025, the trajectory is clear: AI in cancer detection will become more accurate, more accessible, and more integrated into routine care.
Digital Twins and Personalized Medicine
The next wave of AI innovation will create comprehensive “digital twins” of patients—virtual models that integrate genomics, imaging, clinical history, and real-time health data. These digital twins will simulate disease progression and treatment response, allowing clinicians to essentially test different treatment approaches virtually before implementing them in real patients.
Real-Time Clinical Decision Support
Emerging AI platforms will provide continuous, real-time clinical decision support, updating recommendations based on the latest evidence and outcomes from similar patients worldwide. Imagine a system that learns from every case, constantly improving and adapting its recommendations.
Democratizing Access
Perhaps most importantly, AI has the potential to democratize access to high-quality cancer care. Advanced AI systems can be deployed in resource-limited settings, providing expert-level diagnostic support where specialist radiologists and pathologists are scarce. This could help reduce global cancer health disparities and save countless lives in underserved communities.

The Bottom Line: A New Era in Cancer Care
We’re witnessing a fundamental shift in how cancer is detected and diagnosed. AI systems achieving 94-99% accuracy, nationwide deployments showing 17.6% increases in detection rates, and breakthrough devices receiving FDA approval—these aren’t isolated experiments. They’re the new standard of care emerging before our eyes.
The integration of AI into cancer detection represents one of the most significant advances in oncology in decades. Early detection saves lives, and AI is catching cancers earlier, more accurately, and more consistently than ever before.
But perhaps the most important takeaway is this: the technology works best when it amplifies human expertise rather than replacing it. The future of cancer care isn’t human versus machine—it’s human and machine working together to save more lives.
As Dr. Xia from Alibaba’s DAMO Academy put it: “AI is giving medicine a new set of eyes. Where humans might overlook subtle signs in complex scans, these models provide consistent, tireless analysis, and they’re only getting better.”
And they are getting better—faster than anyone predicted. Every month brings new breakthroughs, higher accuracy rates, and more lives saved. The revolution in cancer detection isn’t coming—it’s already here.
Frequently Asked Questions (FAQs)
1. How accurate is AI at detecting cancer compared to human doctors?
Modern AI systems are achieving remarkable accuracy rates that often match or exceed human experts. For example, Harvard’s CHIEF model reached 94% accuracy across multiple cancer types, while the ECgMLP model achieved 99.26% accuracy for endometrial cancer detection—significantly higher than the 78-80% accuracy of traditional human-led diagnosis. However, the best results come when AI works alongside doctors, not instead of them. In the German nationwide breast cancer screening study, AI-assisted radiologists detected 17.6% more cancers than standard screening without AI support.
2. Will AI replace radiologists and pathologists?
No. AI is designed to assist and augment medical professionals, not replace them. While AI excels at processing large volumes of images and identifying patterns, human expertise remains essential for contextualizing findings, managing complex cases, making final diagnostic decisions, and providing compassionate patient care. Studies show that the combination of AI assistance and human expertise produces better outcomes than either alone. AI handles routine screening and flags suspicious cases, allowing doctors to focus their time and expertise where it matters most.
3. Is AI cancer detection available in hospitals now, or is it still experimental?
AI cancer detection has moved from experimental to clinical reality. Multiple AI systems have received FDA approval or clearance, including Paige Prostate (the first FDA-approved AI pathology tool), PathAI’s AISight Dx platform, and Roche’s VENTANA TROP2 RxDx Device. China’s PANDA system received FDA Breakthrough Device Designation in April 2025. The German nationwide study deployed AI across 12 sites involving nearly half a million women. However, availability varies by location, healthcare system, and specific cancer type. Not all hospitals have adopted these technologies yet, but deployment is expanding rapidly.
4. What types of cancer can AI detect?
AI systems can now detect a wide range of cancers, including:
- Breast cancer (through mammography screening)
- Lung cancer (via CT scans and low-dose screening)
- Colorectal cancer (with colonoscopy image analysis and CT imaging)
- Prostate cancer (from biopsy pathology slides)
- Pancreatic cancer (using standard CT scans)
- Stomach cancer (through non-contrast CT imaging)
- Endometrial, ovarian, and bladder cancer (from histopathology images)
- Brain cancers (MRI analysis and tumor characterization)
- Skin cancer (through dermoscopy image analysis)
Some systems like Harvard’s CHIEF model can work across 19 different cancer types, while others are specialized for specific cancers.
5. Does AI cancer detection have any biases or limitations?
Yes, AI systems face several important limitations. Bias is a significant concern—if training data predominantly comes from certain demographic groups, AI may perform less accurately for underrepresented populations (different races, ethnicities, genders, or ages). Data quality matters enormously; AI performance can vary with different imaging equipment or techniques. Interpretability is another challenge—AI often functions as a “black box,” making it difficult to understand exactly why it flagged something as suspicious. Additionally, these systems require high-quality digitized images and significant computational resources. Researchers and regulators are actively working to address these limitations through diverse training datasets, standardized protocols, and explainable AI approaches.
6. How much does AI-assisted cancer screening cost?
Costs vary widely depending on the specific AI system, healthcare setting, and insurance coverage. In many cases, AI-assisted screening doesn’t significantly increase patient costs because the AI is integrated into existing imaging workflows. The German study showed that AI-assisted mammography increased detection rates without increasing recall rates (unnecessary follow-ups), potentially improving cost-effectiveness. Some systems may actually reduce overall healthcare costs by enabling earlier detection (when treatment is less expensive) and reducing the need for multiple radiologist reads. However, initial implementation costs for hospitals can be substantial. As the technology matures and becomes more widespread, costs are expected to decrease.
7. Can AI predict if cancer treatment will work for me?
Yes, increasingly AI systems can predict treatment response with impressive accuracy. Stanford’s MUSK model predicted which lung cancer patients would benefit from immunotherapy with 77% accuracy (compared to 61% for standard methods). Harvard’s CHIEF model successfully predicts patient survival outcomes and identifies genetic mutations related to treatment response. Roche’s computational pathology device helps identify lung cancer patients most likely to benefit from specific targeted therapies. These AI systems analyze combinations of imaging data, pathology slides, genetic information, and clinical history to create personalized predictions. However, these are probabilistic predictions to guide treatment decisions, not certainties—your oncologist will use AI insights alongside clinical judgment and your preferences.
8. What happens if the AI makes a mistake and misses my cancer?
This is a critical question about responsibility and safety. First, it’s important to understand that AI doesn’t work alone—a qualified physician always reviews and makes final diagnostic decisions. Current best practices involve AI flagging suspicious findings for human review rather than making autonomous diagnoses. If a cancer is missed, responsibility typically lies with the healthcare provider who has ultimate diagnostic authority, though legal frameworks are still evolving around AI-assisted medicine. This is why regulatory bodies like the FDA rigorously evaluate AI systems before approval, requiring extensive validation across diverse patient populations. The goal of AI is to reduce missed cancers (and studies show it does), but no detection system—human or AI—is perfect. Regular screening, following recommended guidelines, and communicating any concerning symptoms to your doctor remain essential.
Note: This article provides information about current AI technologies in cancer detection as of 2025. Always consult with qualified healthcare professionals for medical advice specific to your situation. AI systems are designed to assist medical professionals and should not be used for self-diagnosis.










Leave a Reply